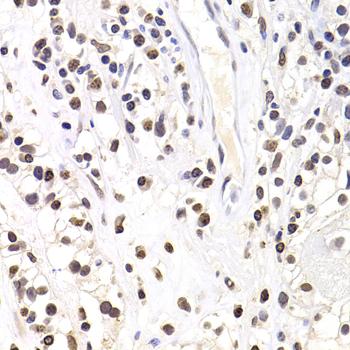
SOX5 Polyclonal Antibody[30782
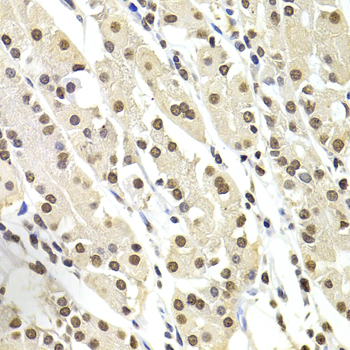
SOX5 Polyclonal Antibody[30782

相关产品推荐更多 >
万千商家帮你免费找货
0 人在求购买到急需产品
- 详细信息
- 技术资料
- 免疫原:
Recombinant fusion protein of human SOX5 (NP_694534.1).
- 形态:
liquid
- 保存条件:
Store at -20˚C
- 克隆性:
Polyclonal
- 适应物种:
Human;Mouse;Rat
- 保质期:
12 months
- 抗原来源:
Rabbit
- 供应商:
南京赛戈巍生物科技有限公司
- 宿主:
Rabbit
- 应用范围:
WB,IHC,IF
- 靶点:
Uniprot:P35711
- 抗体英文名:
SOX5 Polyclonal Antibody
- 规格:
50ul/100ul
计算分子量:70kDa
配方:Avoid freeze / thaw cycles.|Buffer: PBS with 50% glycerol, pH7.4.
应用详情:WB 1:500 - 1:2000
IHC 1:50 - 1:200
IF 1:50 - 1:100
图片:

Western blot analysis of extracts of various cell lines, using SOX5 antibody.
,

Immunohistochemistry of paraffin-embedded rat kidney using SOX5 antibody.
,

Immunohistochemistry of paraffin-embedded human colon carcinoma using SOX5 antibody.
,
Immunohistochemistry of paraffin-embedded human kidney cancer using SOX5 antibody.
,
Immunohistochemistry of paraffin-embedded human stomach using SOX5 antibody.
,

Immunohistochemistry of paraffin-embedded mouse brain using SOX5 antibody.
,

Immunofluorescence analysis of MCF7 cells using SOX5 antibody.
风险提示:丁香通仅作为第三方平台,为商家信息发布提供平台空间。用户咨询产品时请注意保护个人信息及财产安全,合理判断,谨慎选购商品,商家和用户对交易行为负责。对于医疗器械类产品,请先查证核实企业经营资质和医疗器械产品注册证情况。
技术资料暂无技术资料 索取技术资料


![SOX5 Polyclonal Antibody[30782]](https://img1.dxycdn.com/p/s14/2025/0923/305/2150219664296040791.jpg)


![PIF1 Antibody[43903]](https://img1.dxycdn.com/p/s14/2025/0922/568/0046652811090600791.jpg!wh200)
![SNAI2 antibody[38171]](https://img1.dxycdn.com/p/s14/2025/0922/359/6146153295428599691.jpg!wh200)
![CD3G Mouse mAb[63389]](https://img1.dxycdn.com/p/s14/2025/0922/632/2321321568067599691.jpg!wh200)

